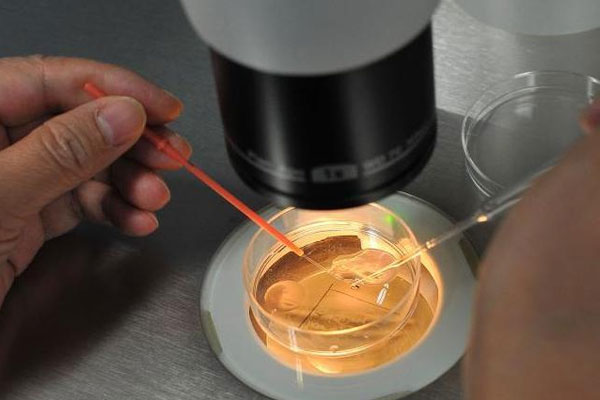
紧急！求做了试管的姐妹告知到底是取卵痛还是宫腔镜痛

-
紧急!求做了试管的姐妹告知到底是取卵痛还是宫腔镜痛
做试管的姐妹们是必须要经历取卵手术的,有的姐妹还需要进行宫腔镜,这些都是很重要的步骤。关于取卵和宫腔镜在网络上面是有很多的说法,最火热的一个话题就是,到底是取卵..
2023-01-22 12:15 -

取卵手术详细过程分享,做试管婴儿的姐妹记得收藏!
关于试管取卵手术,在网络上面一直都存在很多的说法,而且现目前很多关于取卵非常疼、取卵会导致卵巢和女性早衰等信息一直都在流传,这些说法导致了很多姐妹们对试管婴儿望..
2023-01-22 12:20 -
求姐妹分享试管婴儿受精卵等级是怎样划分的?
做试管的时候第一次是直接移植的鲜胚,所以对于胚胎的等级都还不算特别的了解,并且第一次移植完之后才过了一个星期的时间就已经着床成功了,大宝就是这样出生的,现在我们..
2023-03-27 11:18 -
有没有姐妹知道巧囊会影响试管成功率吗?
我自己是在去年的时候,就在医院做检查,查出两侧都有巧克力囊肿,当时就做了手术,手术三个月后开妈备孕,到现在还是没怀上。前几天去医院做检查,结果在上周的时候就复查..
2023-03-27 11:50 -
有姐妹知道试管婴儿双胞胎一般几个月才稳定吗?
我最近做了试管婴儿,移植了三枚胚胎,成功着床两枚,现在已经怀上双胞胎。这段时间我一直比较小心,生怕动到肚子,影响胎儿。连吃饭都是婆婆做好了给我送过来,家里人也非..
2023-03-27 12:43 -
有姐妹知道试管建档当天一般需要交多少钱吗?
我是一个卵巢早衰患者,做了手术,也吃了药调理,但一直就是没有怀孕,也找了很多的名医,跑了很多的医院,心灰意冷,不知道该怎么办。前段时间和老同学聚会的时候,就说起..
2023-03-28 12:33 -
有在天津市中心妇产做试管的姐妹吗?推荐一个试管群呗?
我是河北人,老公是天津人,现在已经定居天津两年。因为不孕不育,现在打算在天津市中心妇产医院做试管婴儿,但是我对这个医院的了解太少了。也不知道具体的流程和费用,所..
2023-03-29 11:24 -
有姐妹知道在丹麦做一次试管婴儿的费用大概是多少吗?
我今年34岁,老公患有精索静脉曲张,目前已经做了手术了,但是现在术后两年多了,始终没有怀上孩子,去复查后医生说我老公的精子质量不是很好,建议我们直接做试管婴儿。朋..
2023-03-29 13:04 -
有经验的姐妹能分享一下秦皇岛试管哪家医院好吗?
初期备孕1年未怀孕后就诊发现输卵管上举,卵巢功能不好后转试管,采取改善拮抗方案,吃达英3521天后正式进入周期,后取卵7,7个全部多精入卵,我对象精液检查全部正常,怀..
2023-03-29 13:07 -
为什么很多做试管生双胞胎的姐妹现在都后悔了?
我不知道从什么开始就一直恐惧生孩子,感觉是拿我的生命进行赌博,但是我老公特别喜欢孩子,觉得这样对老公不公平,就想知道通过做试管怀双胞胎,一次到位,就没有受两次苦..
2023-03-30 11:19 -
有做试管超长方案成功的姐妹吗?求经验分享!
我今年35岁,正在计划试管婴儿备孕,已经做了各方面的检查,医生根据我的情况给我制定了试管婴儿长方案。由于现在年龄也小了,担心试管也不成功,所以想好好的准备,请问一..
2023-03-30 12:58 -
求姐妹分享正常能生育的情况下做试管预算大约多少钱?
我姨妈今年39岁,被诊断为输卵管积水,陆续做了好几次宫腔镜手术,积水却一直反反复复,医生建议她趁着子宫还有生育能力,抓紧把输卵管结扎了做试管婴儿,试管婴儿是给怀不..
2023-03-30 13:15 -
你身边有没有姐妹为了生男孩而选择试管的呢?
因为试管技术的发展和宣传,加上现在全面三胎的发开,我身边的很多人都打算去做试管,要个男孩子,就不能理解了,于是想问一下大家,大家周围的人都是这样的吗?还是说只有..
2023-03-31 13:07 -
有姐妹说做试管婴儿可以选择性别是真的吗?
家里已经出生了两个女儿了,刚开始第一个孩子的时候大家还是比较开心的,毕竟家里女孩还是比较少的,后面优生了一个女儿,长辈的脸色就有点难看了,后面又出现了一次流产,..
2023-04-02 12:37 -
有姐妹知道第一次去医院做试管婴儿应该挂什么科吗?
我今年40岁,爱人44岁,正在二胎备孕中,但是检查发现amh值0.71,之前有过两次胎停,2007年8月一次三体,2020年10月一次三体,免疫去年查過,封閉抗體陰性,糖耐量0时4.28..
2023-04-02 13:10 -

你身边有没有腺肌症试管成功的姐妹,请经验分享!
备孕前我和老公在医院做了一系列的检查,最后查出我患有子宫腺肌症,医生建议我做试管婴儿,我但是我已经移植失败一次了,主要原因是胚胎质量不好,调理后还是质量还是不好..
2023-04-05 11:15 -
有在阜阳市人民医院做过试管的姐妹吗?求具体费用!
我28岁,和老公结婚3年多至今没怀孕,之前也是没怀过孕,去年查出有轻微多囊卵巢综合症做过一次促排没成功,就去检查了查出输卵管发现双侧通而不畅,所以打算去做试管婴儿..
2023-04-08 12:26 -
有没有姐妹可以推荐一个比较靠谱的做第三代试管婴儿app啊?
有没有姐妹可以推荐一个比较靠谱的做第三代试管婴儿app啊?我有一个远房的表姐,我跟他是真的是从小就比较的亲,表姐就比我大几岁,有一次我们在聊天的时候,他给我说自己..
2023-04-08 13:24 -
有试管经验的姐妹说说试管婴儿空囊的概率高吗?
我和老公因为年龄比较大了自然受孕比较困难,所以我们准备做试管婴儿。最近我在网上做了很多功课,我看到不少网友都说自己出现了空囊的情况,就是无胎心胎芽,说的我也有点..
2023-04-10 11:34 -
亲身经历过试管移植失败的姐妹能说说初期表现有哪些吗?
我今年29岁,因为备孕很长一段时间都没有怀孕,所以我去医院做了去那面的体检,结果发现我的子宫环境都是没有问题的,但是我患上了卵巢早衰,所以现在受孕比较困难,医生建..
2023-04-10 12:29
微信分享
扫描二维码分享到微信或朋友圈